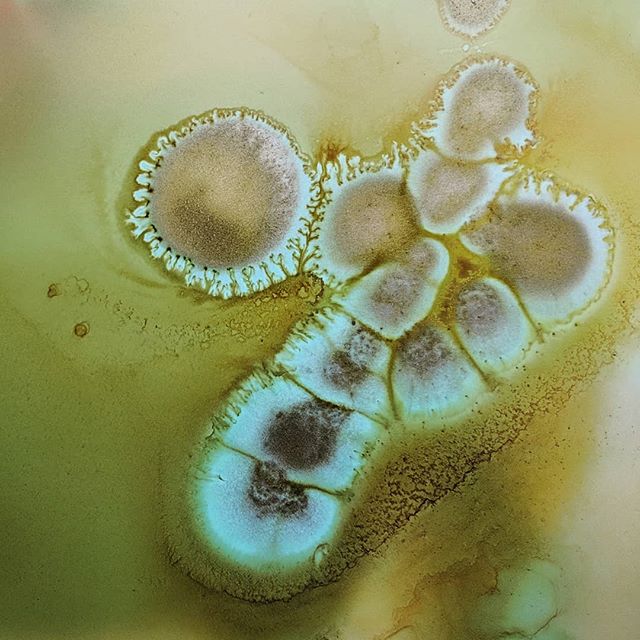

When they studied him, the ologists all posed different theories. It was the distillation of his most pure essence, said the spiritualists; a solution of precious sadness. A nutritionist from Belgium maintained he had accumulated a surplus of trace elements that could not be excreted through normal means. They drew sample after sample from his arms, his liver, his eyes and nasal passages until he was so pale and exhausted he was forced to refuse visitors for a month. In that time, he became more productive than ever.
Some pilgrims simply wanted to visit the humble cottage where he still lived. Others, to breathe the same air as him. But most wanted to see the phenomenon for themselves. Once witnessed, those who arrived sceptical left speechless, and those who were already fans chattered and squealed the whole coach ride home.
Most days he would sit in his living room, modified as it had been with a wide glass viewing panel in place of a back wall. His face was connected to the breathing apparatus and the vacuum machine. On the widescreen television in front of him, the sad footage looped, from momentary miseries to unimaginable woes. Stories of soldiers killed in action. Of mothers who must choose which starving child to keep alive. Of lost soulmates, adopted babies and failed operations on beloved pets. It was relentless.
Each tear trickled down his cheek and hung on his jawline, from where it was siphoned hungrily down a tube and into the collection chamber. The vessel stood proudly on display in full view of the curious crowds. Two, three, even four times a minute, the surface shimmered as one tear dripped luxuriously into the rest. Pure gold.